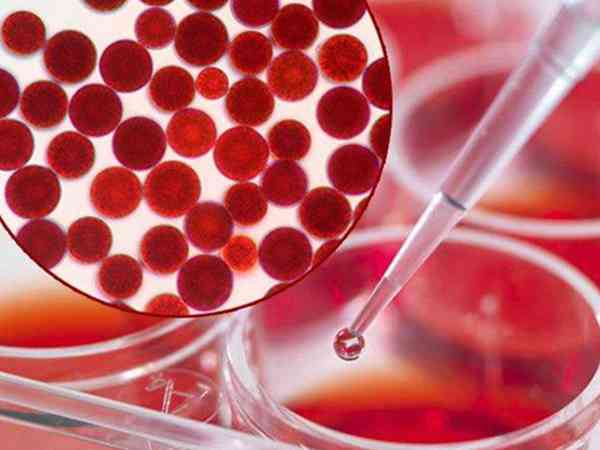

日本试管婴儿

2023日本全国十大试管机构排名,人生夙愿实现的最佳机构
目前有很多人都有生育方面的问题,所以对于辅助生殖技术的需求量也越来越大,试管婴儿是辅助生殖的一种,现在试管婴儿技术虽然说发展的不错,不过国内的成功率总体水平保持在40%-50%左右,而国外由于技术先进,所以成功率也更高,所以说越来越多的患者前往国外做试管,日本就是一个很不错的选择,目前日本试管成功率比国内高不少,能够满足不孕患者的生育需求。日本试管婴儿医院排名日本的试管婴儿技术很不错,成功率相比国...

试管婴儿技术最先进的日本和美国到底哪个更好一些?
美国的试管婴儿技术更好。虽然日本和美国都是采用的第三代试管技术,但美国采用的NGS技术可以检测出包括地中海贫血和唐氏综合征在内的255种遗传病,而且还可以合法地筛选性别。不过日本试管技术的硬件设备非常严格,日本有些医院会用400倍显微镜监测精子质量,在400倍显微镜下可以清楚的看到精子是否有缺陷。日本试管婴儿技术相较于美国试管婴儿技术发展较晚,且医疗资源有限,所以在医疗资源分布上相较于美国来说处于...

2023去日本做一次试管婴儿不算机票要多少钱?
2022年想去日本做试管婴儿需要准备8-12万左右,但要注意这只是做一次所涉及到的费用,如果女性在接受治疗期间因某种原因治疗失败,那么在接受第二次治疗时需要额外支付一些费用。如果第一次没有多余的胚胎,就需要再次从促排卵开始进行,那么费用就相当于翻倍。所以说,要去日本做试管建议多准备一些金钱。日本做试管婴儿费用都是透明的,如:取卵、麻醉、胚胎培育等,都有各自的价格。而一般做试管婴儿的费用也就是包括身...

2023去日本做一次三代试管婴儿费用大概要花多少?
根据目前日本某家医院的试管婴儿价目表来看,在日本做三代试管婴儿收费并不算贵,其价格与比国内会稍贵一些,但也比美国、丹麦等国便宜不少。前期检查费用在10000元左右,采用不同促排卵方案价格会有所不同,微刺激方案促排和取卵费在40000元左右,长方案在60000元左右……胚胎pgs筛查是10000元/颗,试管移植手术费在30000元左右。日本作为发达国家和亚洲闻名的“少子国”,拥有庞大的试管婴儿群体,...

做试管婴儿移植手术前医生建议吃虾青素的好处是什么?
试管前吃虾青素对生殖方面有帮助,所以日本医生建议在试管前吃。虾青素在生殖中的作用有:能够改善生殖内分泌功能;虾青素辅助治疗可以改善DOR患者卵巢储备功能,提高卵巢反应性,改善IVF治疗结局;能清除生殖系统内过多的自由基(ROS);虾青素能降低精子DNA碎片率;还能促进精子获能、提高顶体反应(AR)发生率。虾青素(AST)是一种天然红色的类胡萝卜素,虾青素广泛存在于自然界,如大多数甲壳类动物和鲑科鱼...
要生二胎可以去日本做三代试管婴儿选性别生儿子吗?
是可以的,日本这个国家对于试管婴儿技术的把控并不严格,在该国家做三代试管支持性别选择,也就是说你只要在日本能做三代试管的医院接受治疗,那么都是可以选择性别的。其实日本法律上对于选性别有相关限制,但实际上是可以进行操作的。就比如日本英医院就可以选择性别,日本当地人即便做了三代也不会告诉性别的,而该医院给国际患者打了一个擦边球,三代报告会直接发回本人,可以看出胚胎性别,然后移植想移植的胚胎就好。第三代...

单身女性去日本英医院做试管婴儿费用是多少?
日本英医院试管费用在9-11万元左右/周期。日本英医院试管收费是按阶段来的,双方首诊共1.1万,然后如果选择微刺激方案1次,那么促排+取卵+取精+受精+培养就是4.5万左右,最后移植是3.3万,加起来大概就是9万,然后因为每个人情况不同,促排用药有区别,所以导致费用有差异,而且要进行胚胎筛查的话,就要再加上1万人民币/颗的胚胎检测费。日本英医院将试管婴儿费用分为了很多小项,每项都有明确的价格,如:...

日本英医院和衫山医院哪个做试管婴儿的技术更好?
日本杉山和英医院做试管婴儿都比较好,其实哪家医院好,是要看每个人的选择侧重点的。日本杉山和英医院做试管都是靠谱的,医疗环境都是很舒适的,不过英医院的规模更大,设备也先进,做一次试管婴儿成功率在65%左右,治疗达到3次成功率可达89.7%,而杉山医院的成功率也是挺高的,特别是第三代试管婴儿技术,35岁以下综合成功率能达到80%。日本英医院生殖中心地址位于日本大阪神户,日本杉山医院位于东京千代田区,两...

不孕不育去日本做三代试管婴儿养囊的成功率高吗?
日本医院做三代试管婴儿的成功率在40%~60%之间,这与国内医院的成功率是差不多的。不过在日本的医院的三代试管婴儿设备与技术会比国内大部分医院好,大部分医院都是配备的Time Lapse胚胎培养系统,还有Piezo-ICSI显微受精技术与SEET移植法,可以尽可能提高胚胎存活率,在一定程度上也能提高怀孕的三代试管移植成功率。日本作为发达国家,其医疗技术发展的也是非常不错的,在三代试管婴儿技术方面,...

本人没结婚证想去日本做试管婴儿也需要提供结婚证吗?
日本英医院做试管不需要结婚证。日本当地的法律政策开放,做试管婴儿只需要有护照即可,也就是说日本也是允许单身人士做试管婴儿的。其实除了国内做试管婴儿比较严格外,需要有三证(结婚证、身份证、准生证),还必须满足做试管的病症,且禁止选性别,国外的一些国家(如美国、俄罗斯、柬埔寨等)做试管婴儿的要求都是比较少的,一般只需要提供护照即可,不过具体的情况还是建议咨询要做试管的医院,毕竟每个医院的要求有差异。要...

日本试管婴儿医院排名中哪家养囊技术比较好?
日本英医院和杉山医院是做试管婴儿排名比较好的医院,2022年想要去日本做试管婴儿的话,可以选择这两家医院。日本英医院和杉山医院都可以进行第一代、第二代和第三代试管婴儿技术,这两家医院做试管婴儿的成功率都是比较高的,都在65%左右。不过每家医院都有自己的特色,选择合适自己的才是好的。一般来说,患者在选择医院的时候,首先考虑的就是成功率,而规模大、医资雄厚、医疗设备种类多且精密度高、专业医生较多的医院...

看了又看